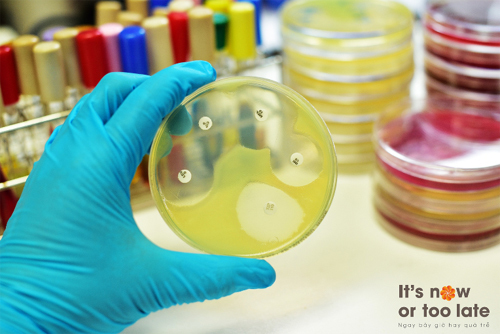
{keywords}

Năm 2050 số người tử vong do đề kháng kháng sinh có thể tăng lên tới 10 triệu người/năm. Hãy phòng chống đề kháng kháng sinh ngay từ hôm nay nhằm giảm thiểu tỷ lệ tử vong cũng như gánh nặng kinh tế toàn cầu.
![]() |
|
Lạm dụng kháng sinh đang diễn ra trên toàn thế giới |
Ngược với tốc độ kháng thuốc đang gia tăng ngày càng nghiêm trọng của các chủng vi khuẩn đề kháng thuốc và/hoặc đa kháng thuốc, việc phát triển các kháng sinh mới đã chững lại từ hơn 30 năm nay và chỉ có một vài kháng sinh mới được giới thiệu ra thị trường toàn cầu.
Trong báo cáo của Lord Jim O’Neill vào tháng 5/2016, theo tình hình đề kháng thuốc hiện nay, nếu không có những hành động can thiệp kịp thời thì vào năm 2050 số người tử vong do đề kháng kháng sinh có thể tăng lên tới 10 triệu người/năm.
Hành động ngay bây giờ
“Nếu chúng ta không làm gì để giải quyết vấn đề này, tổn thất với nền kinh tế thế giới có thể lên tới 100.000 tỷ USD và điều này có thể đánh dấu sự kết thúc với một nền y học hiện đại mà chúng ta đã từng biết.", Thủ tướng Anh, ông David Cameron đã phát biểu trong cuộc họp báo tại Hội nghị G7 ở Nhật Bản.
![]() |
|
Phòng chống đề kháng kháng sinh cần thực hiện ngay từ hôm nay |
Tháng 5/2015, WHO cũng đã đưa ra lời kêu gọi phối hợp hành động trên phạm vi toàn cầu, cần sự kết hợp đồng bộ của chính phủ, các cơ quan y tế, bệnh nhân, các công ty dược phẩm và những ban ngành có liên quan khác.
Đáp ứng lời kêu gọi đó, tháng 1/2016, tại Davos, 83 công ty dược phẩm lớn trên thế giới, cùng ký tên vào Tuyên Ngôn Công Nghiệp về phòng chống Đề Kháng Kháng Sinh, đặt ra hàng loạt các cam kết cụ thể để giảm sự phát triển và lan tràn của các chủng vi khuẩn đề kháng kháng sinh, đầu tư vào nghiên cứu và phát triển (R&D) các nghiên cứu liên quan đến đề kháng kháng sinh, đồng thời nâng cao khả năng tiếp cận với thuốc kháng sinh một cách hợp lý hơn trong cộng đồng trên thế giới.
Nhà sản xuất & cung cấp dược phẩm đóng vai trò gì?
Tại UNGA tháng 9/2016, GSK đưa ra cam kết trong lộ trình phòng chống đề kháng kháng sinh toàn cầu, khuyến nghị đưa vấn đề này trở thành một bước bắt buộc trong quá trình giải quyết các thách thức về chăm sóc sức khỏe trên toàn thế giới.
Cam kết của GSK xoay quanh ba nhiệm vụ chính: ngăn ngừa nhiễm khuẩn nhằm làm giảm sự phụ thuộc của cộng đồng vào kháng sinh; phát triển nhiều phương pháp điều trị sáng tạo và một môi trường R&D kháng sinh sôi động hơn; xây dựng một môi trường kinh doanh bền vững nhằm khuyến khích sử dụng và đầu tư hợp lý trong công cuộc phòng chống đề kháng kháng sinh.
Chủ động phòng bệnh luôn tốt hơn chữa bệnh. GSK chú trọng nghiên cứu và cung cấp các loại vacxin phòng chống và ngăn ngừa bệnh lây nhiễm do cả vi khuẩn và virus, cam kết tạo điều kiện để người dân tiếp cận vacxin phòng bệnh tốt nhất .
GSK cũng tham gia vào nhiều dự án liên quan đến cộng đồng, phối hợp với nhiều đơn vị y tế ở các nước để thực hiện nhiều chương trình huẩn luyện, phối hợp cùng các Hiệp Hội Y Khoa chuyên ngành tổ chức các hội thảo khoa học nhằm tuyên truyền, vận động ngăn ngừa và kiểm soát đề kháng kháng sinh. Đồng thời, GSK không cấp phép cho các kháng sinh của tập đoàn được sử dụng trong nông nghiệp/chăn nuôi; và đảm bảo các đơn vị cung ứng sản xuất thuốc - vacxin của tập đoàn trên toàn cầu tuân thủ nghiêm ngặt các quy trình xử lý chất thải kháng sinh đúng đắn.
![]() |
|
Nghiên cứu và phát triển kháng sinh mới cần được tiếp tục không ngừng |
Trong lĩnh vực R&D, GSK cam kết đầu tư nghiên cứu nhằm điều trị hiệu quả các bệnh nhiễm khuẩn, hỗ trợ các quá trình thử nghiệm lâm sàng tại nhiều quốc gia cũng như đóng góp ý kiến xây dựng những chính sách nhằm làm giảm các rào cản pháp lý đối với đầu tư sản xuất và phân phối kháng sinh trên toàn thế giới.
Công trình khảo sát về Đề Kháng Kháng Sinh (SOAR) do GSK tiến hành từ 2002 đã được đón nhận và nhân rộng ra trên 31 quốc gia với 54 trung tâm nghiên cứu vi sinh. Đây là nguồn cung cấp các dữ liệu hữu ích giúp cập nhật định kỳ tình hình đề kháng kháng sinh, giúp các Hiệp Hội Y Khoa xây dựng các phác đồ điều trị ngày càng hiệu quả hơn, góp phần vào nghiên cứu & phát triển những loại thuốc kháng sinh mới, hỗ trợ việc điều trị nhiễm khuẩn ở nhiều nước và phòng chống đề kháng kháng sinh trên toàn cầu.
Những cam kết của GSK trên nền tảng xây dựng và phát triển lâu dài trên toàn thế giới sẽ hỗ trợ các mục tiêu toàn cầu về cải thiện sức khỏe cộng đồng, kiểm soát nhiễm khuẩn tích cực hơn và phòng chống đề kháng kháng sinh hiệu quả hơn trong chiều hướng chung của cả thế giới để đạt đến sự thịnh vượng và phát triển bền vững vào năm 2030.
|
Nhân tuần lễ “Toàn cầu nhận thức về kháng sinh”, VPĐD GSK Tp. HCM phối hợp cùng Hội Hô hấp TP. HCM thực hiện hội thảo trực tuyến Diễn đàn Nghiên cứu SOAR Toàn cầu 2016 với chủ đề “Đề kháng kháng sinh - Vấn đề toàn cầu” với sự tham gia của 38 quốc gia như Singapore, Việt Nam, Nga, Ukraine v.v |